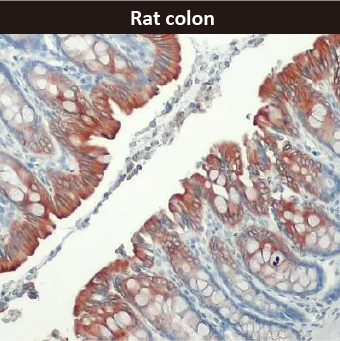

Muscle-Derived SEVs Drive Liver Fibrosis in Overtraining
![]() |
While regular exercise supports metabolic health, excessive physical training (i.e., overtraining) can have deleterious effects that include liver injury. The mechanisms underlying overtraining-induced hepatic pathology have remained elusive.
In a recent Cell Metabolism study, Liu et al. reveal a novel muscle-liver axis in which skeletal muscle-derived small extracellular vesicles (SEVs), termed “lactate bodies,” can cause hepatic fibrosis in the context of overtraining (1). Through integrated human cohort analysis, murine overtraining models, and in vitro experiments, the authors show that sustained lactate accumulation in muscle induces SORBS3/Vinexin lactylation and liquid-liquid phase separation, promoting FBXO2 sorting into SEVs. These vesicles are subsequently delivered to the liver, where FBXO2 mediates MCL1 degradation, triggering BAX/BAK-dependent hepatocyte apoptosis and hepatic stellate cell (HSC) activation. Muscle-specific deletion of Sorbs3 or Fbxo2, or treatment with the lactate-lowering agent salidroside, markedly attenuated lactate body production and liver fibrosis.
This work defines a mechanistic link between muscle metabolic stress and liver fibrosis, identifying lactate bodies as potential therapeutic targets to prevent overtraining-associated hepatic injury.
GeneTex offers outstanding antibodies for signaling pathway research, including the Vinexin antibody [N3C2] (GTX115362) cited in this study. Please explore our comprehensive antibody catalogs for signaling pathways, or visit the GeneTex website for the most current product listing relevant to your work.
|
Highlighted Products |
|
|
|
|
||||||||||||||||
Reference:
| 1. Cell Metab. 2025 Apr 1;37(4):824-841.e8. doi: 10.1016/j.cmet.2024.12.005. |